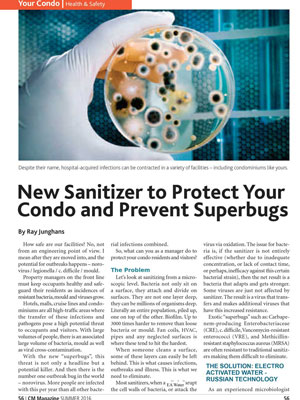

Health Sector
Non chemical and Natural disinfection, sanitization and antiseptic HOCL WATER with neutral PH
(Anolyte or AQUASOL or Aqualyte or Hypochlorous or Mixed oxidants or Super Oxidant Water or GT SOL or Pathocidal)
COMPARISION OF OUR PATHOCIDAL OVER OTHER AVAILABLE DISINFECTANTS
| DISINFECTANT | DESCRIPTION | LIMITATIONS |
|---|---|---|
| Chlorine | Used in a gaseous state, requires strictest safety measures |
• Strict requirements for transportation and storage • Potential danger for health in case of a leak. • Formation of disinfection by-products, such as chloroform, trihalomethanes (THMs) and haloacetic acids (HAAs), are both carcinogenic in large quantities and are regulated by the United States Environmental Protection Agency (EPA) and the Drinking Water Inspectorate in the UK. Although chlorine is effective in killing bacteria, it has limited effectiveness against pathogenic protozoa that form cysts in water such as Giardia lamblia |
| Hypochlorite | Used in liquid and granulated forms (trade concentration - 10-20%), can be obtained on site, electrochemically |
• Ineffective against cysts (Giardia, Cryptosporidium) • Loses its activity during long-term storage • Forms trihalomethane. When on-site generated, requires either immediate use or, in case of storage, special measures to purify the initial water from heavy metals ions. When on-site generated, NaCIO solution with the active chlorine concentration more than 450 mg/l form chlorates during storage • Sodium hypochlorite is a dangerous and corrosive substance. • While working with sodium hypochlorite, safety measures have to be taken to protect workers and the environment. • can cause acute respiratory effects • Sodium hypochlorite should not come in contact with air, because that will cause it to disintegrate |
| Chlorine dioxide | On-site generation only. The most effective disinfectant and strongest oxidation agent among all chlorine-containing ones |
• On-site generation only • Requires transportation and storage of chemicals • In reaction with organic impurities forms nonorganic by-products • Forms chlorates and chlorite ions • chlorine dioxide gas accumulations may spontaneously detonate. |
| Chloramine | Formed during the reaction of ammonium with active chlorine. It is used as a disinfectant of a prolonged activity |
• Weak disinfectant and oxidation agent compared to chlorine • Not effective against viruses and cysts (Giardia, Cryptosporidium) • Considerable dosages and prolonged contact time are required for disinfection • Dangerous for patients using dialyzers, because it is capable of penetrating the dialyzer membrane and effect erythrocytes • Forms nitrogen-containing by-products • Water distribution systems disinfected with chloramines may experience nitrification, as ammonia is a nutrient for bacterial growth, with nitrates being generated as a by-product. |
| Ozone | Has been used for several decades in some of European countries for the purpose of disinfection, elimination of color, for the taste and odor control |
• Forms byproducts, including: aldehydes, ketones, organic acids, bromine-containing trihalomethanes, (bromoform inclusive), bromates (in presence of bromides): peroxides, brom-acetic acid • Necessitates the use of biologically active filters to remove byproducts • Does not ensure residual disinfection effect • Requires significant initial expenses for the equipment • Considerable expenses for operators` training and installation support • When reacting with organic compounds, ozone disintegrates them into smaller components, which could become a feeding media for microorganisms` growth in water distribution systems |
| Ultraviolet | Exposure of water to UV rays capable of killing various types of microorganisms |
• No residual effect • Not efficient against cysts (Giardia, Cryptosporidium) • Requires considerable expenses for the equipment and technical maintenance • Requires considerable operational (power) expenses • Disinfection activity depends on the water turbidity, its hardness (sediments on the bulb surface), precipitation of organic impurities on the bulb surface, and deviations in the power supply, which effect the wavelength variation |
| Alcohol based disinfectant | It is mainly used as sanitising liquid with composition of ethyl or isopropyl alcohol |
• Should be stored from out of reach of children, alcohol toxicity can lead to poisoning and even death • When used too frequently, alcohol-based hand sanitizers can wash away your skin’s natural oils, which can cause drying and cracking. Dehydrated skin can be unattractive and irritating, and it is likely to cause one or more of the following symptoms, Itching, Slight to severe flaking, scaling, or peeling, Fine lines or cracks • alcohol-based hand sanitizers are classified as Class I Flammable Liquid substances, which means they have a flashpoint of less than 100 degrees Fahrenheit”. OSHA has specific guidelines regarding the storage and use of these flammable liquids. |
| Formaldehyde | - |
• extremely pungent and suffocating odour • skin and mucous membrane irritant • can cause allergic dermatitis |
| Quaternary Ammonium Compounds | - |
• Decreased activity against Gram (-) microbes • Lack tuberculocidal properties • No sporicidal activity • Poor activity against hydrophilic viruses • Poor activity against pseudomonads • Development of resistant bacterial strains • Not effective against all nosocomial infections • Incompatible with soaps • Substantial interference by organic matter • Inactivated by stoppers, gauze, cotton, etc. • Reports of contact dermatitis |
The Pathocidalpossess the advantages of other biocidal alternatives without their above mentioned disadvantages.
Pathocidal is a mixed-oxidant solution having ORP +700mv to +1000mv with major constituent Hypochlorous. It exhibits behavioural traits associated with a more active chlor-oxygen chemistry than traditional chlorine. In contrast to other disinfectant technologies, mixed oxidants Pathocidal offer superior disinfection efficacy against all known pathogens in world. It effectively eliminates biofilm in drinking water and other water bodies, It does not produce any byproducts. It is very mild to humans and animals, does not cause any sideffects when applied. It can be applied on any surfaces (like Stainless steel, rubber, wood etc..)
MATERIAL SAFETY DATA SHEET (MSDS): BIO SANITIZER (91/155/EWG)
Section 1 - Product and company identification
Trade name : BIO SANITIZER
Section 2 - Composition and information about ingredients
BIO SANITIZER contains active chlorine compounds such as HClO and ClO- as well as various hydroxyls and hydroxyl radicals such as HO-2, HO2•,HO•, H2O2 and oxygen compounds such as O2, O3, 1O2 in the range of 0.04-0.06% . The average/standard amount of active chlorine/mixed oxidising agents is 0.05%. The solution contains no compounds as per the regulations for toxic compounds (67/548/EWG)
Section 3
| Ingredient CAS Number ~ | EINICS No | Volume % | Symbols | |
|---|---|---|---|---|
| Hypochlorous Acid | CAS No 7790-92-3 | 232-232-5 | 0.025-0.03% | HClO |
| Water | CAS No 7732-18-5 | 231-791-2 | 99.95% | H2O |
| Peroxide, Ozone, oxygen, singlet oxygen 1, O2, clo2, OCl are | 0.02-0.025% |
The solution contains no compounds as per the regulations for toxic compounds.
Section 4 - Hazards identification
The solution is classified as non-dangerous according to 88/279/EWG
Main Hazards:
BIO SANITIZER in the strongest form (C.active >800mg/l) may cause slight irritation to the eyes, sensitive skin and throat. When the solution is stored in bottles, one should not try to smell or inhale the evaporations.
Health affects Eyes:
BIO SANITIZER in the strongest form may cause slight irritation to eyes.
Health effects Skin:
BIO SANITIZER in the strongest form may cause slight irritation to sensitive skin or open wounds.
Health effects ingestion:
Swallowing of the solution in its strongest form may cause slight irritation to a throat and digestive tract. Just drink water to neutralize the irritation.
Section 5 - First aid measures
Eye contact:
Where irritation occurs, flush with cool fresh water
Skin Contact:
Where irritation occurs wash the skin with soap and water
Ingestion:
Drink cool fresh water to flush through and dilute
Inhalation:
Move to fresh air. If dizziness or nausea persists seek medical attention
Section 6 - Fire- fighting measures
There are no special requirements for this solution. No alcohol - Not flammable
Section 7 - Accidental release measures
Personal precautions:
None
Environmental precautions:
The solution is biodegradable so there are no potential risks to the environment
Spillage:
Wipe up with disposable towels there are no special disposal instructions.
Section 8 - Storage
Store in a cool, dry, ventilated area in sealed plastic containers or glass containers and ensure the solution is labelled correctly. Avoid exposure of liquid to direct sunlight.
Section 9 - Chemical and Physical Properties
| Physical state | Liquid |
| Colour and Appearance | Clear, transparent liquid (like water) |
| Odour | Slight chlorine smell varying with the strength of the solution |
| Solubility in water | Completely soluble |
| PH-values | 5.0 to 7.0 |
| Melting point | 0°C |
| Boiling point | 100°C |
| Fire-focus | N/A |
| Flammability | None |
| Explosive | N/A |
| Density | appr. 1,000 kg.m3 |
| Steam-pressure | appr. 2,330 Pa |
Section 10 - Stability and Reactivity
Stability:
Stable under all normal storage conditions. Avoid exposure of liquid to direct sunlight.
Materials to avoid:
The solution does not react with other materials
Hazardous decomposition products:
None
Section 11 - Toxicological information
Acute toxicity:
Non-toxic
Irritant-Eyes:
Data for related material suggests this could produce conjunctivitis irritation
Irritant-Skin:
Data for related material suggests this may cause skin irritation
Reproductive and developmental:
None known
Skin contact:
The possibility of slight allergic sensitisation should be considered in high concentration
Chronic toxicity/Carcinogens:
None
Human Data:
Inhalation may cause respiratory irritation at high concentration
Section 12 - Environmental information
Eco toxicity:
Destroys bacteria, spores, fungi, viruses, parasites and biofilm.
Degradability and Persistence:
Fully biodegradable.
Bioaccumulation:
None
Mobility:
None
Section 13 - Disposal procedures
There are no special disposal procedures
Section 14 - Transport procedures
Not classified as hazardous for transport
Section15 - Regulatory Information
Not listed
Section 16 - Other Information
The information in this document meets the European and Intl requirements for safety and health measurements (91/155/EWG)
The information contained in this document is based on the data considered to be accurate at the time of publication and is given free of charge. It is representative for typical product but batches may exhibit minor variations.